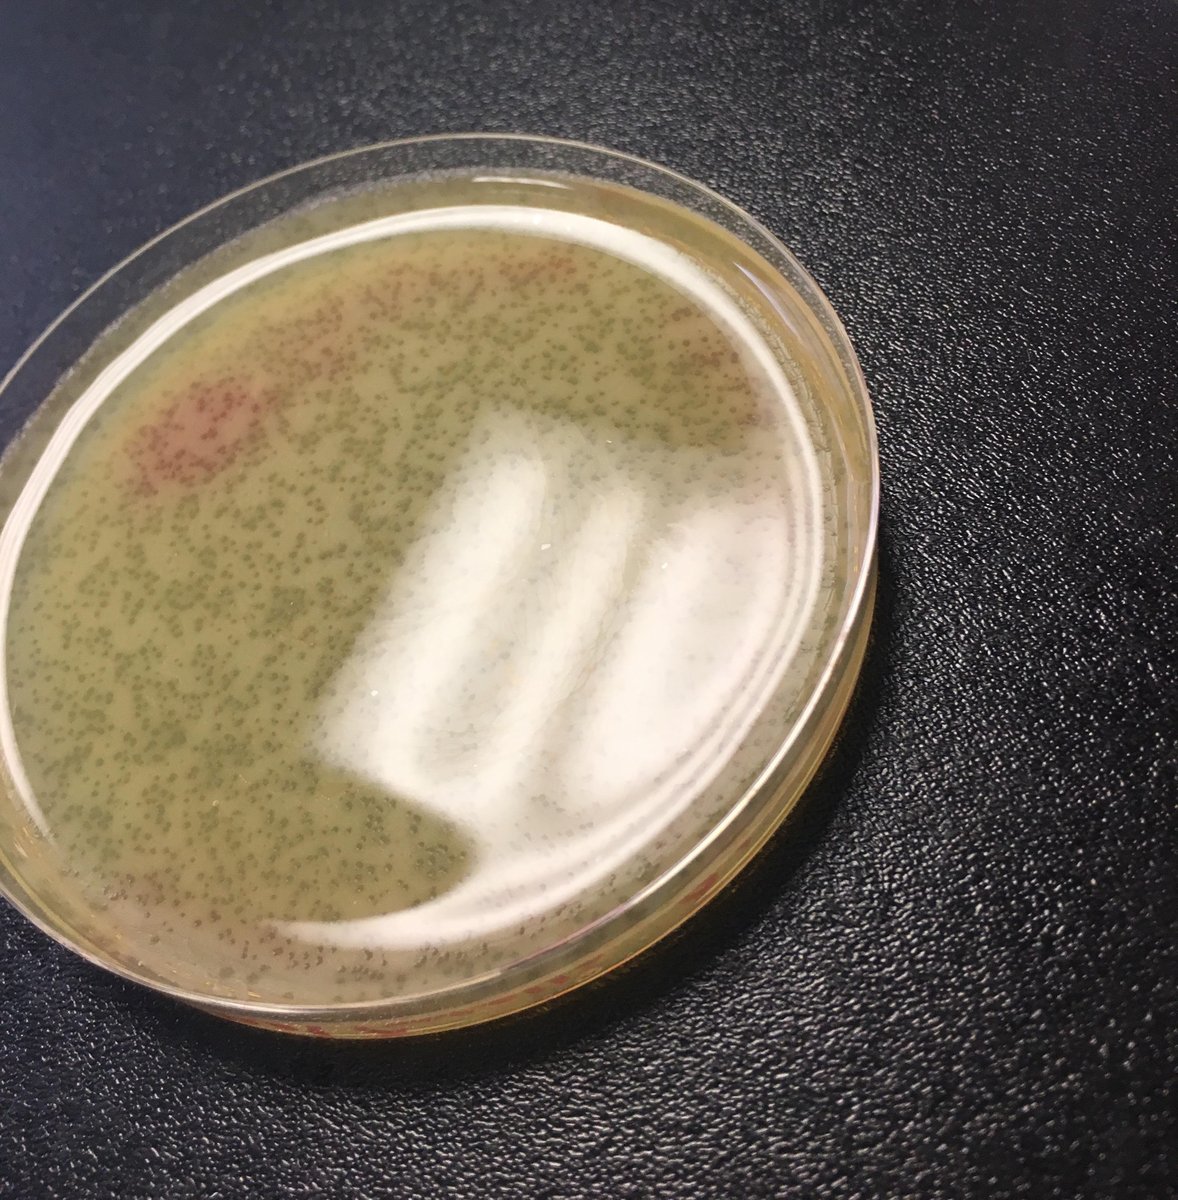

ಟ್ವೀಟ್ಗಳು
- ಟ್ವೀಟ್ಗಳು, ಪ್ರಸ್ತುತ ಪುಟ.
- ಟ್ವೀಟ್ಗಳು & ಪ್ರತಿಕ್ರಿಯೆಗಳು
- ಮಾಧ್ಯಮ
ನೀವು @GHatfull ಅವರನ್ನು ತಡೆಹಿಡಿದಿರುವಿರಿ
ಈ ಟ್ವೀಟ್ಗಳನ್ನು ವೀಕ್ಷಿಸಲು ನೀವು ಖಚಿತವಾಗಿ ಬಯಸುವಿರಾ? ಟ್ವೀಟ್ ವೀಕ್ಷಣೆಯು @GHatfull ಅವರ ತಡೆತೆರವುಗೊಳಿಸುವುದಿಲ್ಲ
-
Graham Hatfull ಅವರು ಮರುಟ್ವೀಟಿಸಿದ್ದಾರೆ
Apply now for our PhD program in Biological Sciences. Great science, mentoring and career development. Application deadline is December 9, 2018 for the Fall 2019 class.
#GRExit https://www.biology.pitt.edu/graduate/how-apply …ಧನ್ಯವಾದಗಳು. Twitter ಇದನ್ನು ನಿಮ್ಮ ಕಾಲರೇಖೆಯನ್ನು ಉತ್ತಮಗೊಳಿಸಲು ಬಳಸುತ್ತದೆ. ರದ್ದುಗೊಳಿಸುರದ್ದುಗೊಳಿಸು -
Graham Hatfull ಅವರು ಮರುಟ್ವೀಟಿಸಿದ್ದಾರೆ
Applications to join the SEA-PHAGES undergrad research program are OPEN! Learn more and apply today: http://bit.ly/2xzcNAp http://bit.ly/2xzcNAp
#SciEd#STEM#STEMeducationpic.twitter.com/mBLaroWaOv ಧನ್ಯವಾದಗಳು. Twitter ಇದನ್ನು ನಿಮ್ಮ ಕಾಲರೇಖೆಯನ್ನು ಉತ್ತಮಗೊಳಿಸಲು ಬಳಸುತ್ತದೆ. ರದ್ದುಗೊಳಿಸುರದ್ದುಗೊಳಿಸು
ಧನ್ಯವಾದಗಳು. Twitter ಇದನ್ನು ನಿಮ್ಮ ಕಾಲರೇಖೆಯನ್ನು ಉತ್ತಮಗೊಳಿಸಲು ಬಳಸುತ್ತದೆ. ರದ್ದುಗೊಳಿಸುರದ್ದುಗೊಳಿಸು -
Graham Hatfull ಅವರು ಮರುಟ್ವೀಟಿಸಿದ್ದಾರೆ
Applications to join the SEA-PHAGES undergrad research program are OPEN! Learn more and apply today: http://bit.ly/2xzcNAp
#SciEd#STEM#STEMeducationpic.twitter.com/GdOhaRTe1o ಧನ್ಯವಾದಗಳು. Twitter ಇದನ್ನು ನಿಮ್ಮ ಕಾಲರೇಖೆಯನ್ನು ಉತ್ತಮಗೊಳಿಸಲು ಬಳಸುತ್ತದೆ. ರದ್ದುಗೊಳಿಸುರದ್ದುಗೊಳಿಸು
ಧನ್ಯವಾದಗಳು. Twitter ಇದನ್ನು ನಿಮ್ಮ ಕಾಲರೇಖೆಯನ್ನು ಉತ್ತಮಗೊಳಿಸಲು ಬಳಸುತ್ತದೆ. ರದ್ದುಗೊಳಿಸುರದ್ದುಗೊಳಿಸು -
Graham Hatfull ಅವರು ಮರುಟ್ವೀಟಿಸಿದ್ದಾರೆ
Applications open for SEA-PHAGES (SEA-Phage Hunters Advancing Genomics and Evolutionary Science) course in 2019; Science Education Alliance | http://HHMI.org http://bit.ly/2NjYZo0
ಧನ್ಯವಾದಗಳು. Twitter ಇದನ್ನು ನಿಮ್ಮ ಕಾಲರೇಖೆಯನ್ನು ಉತ್ತಮಗೊಳಿಸಲು ಬಳಸುತ್ತದೆ. ರದ್ದುಗೊಳಿಸುರದ್ದುಗೊಳಿಸು -
Graham Hatfull ಅವರು ಮರುಟ್ವೀಟಿಸಿದ್ದಾರೆ
Great day of virology in Pittsburgh for the Annual Review of Virology editorial meeting, including
@HarmitMalik@GHatfull et al.pic.twitter.com/M2RJ4HplSW


 ಧನ್ಯವಾದಗಳು. Twitter ಇದನ್ನು ನಿಮ್ಮ ಕಾಲರೇಖೆಯನ್ನು ಉತ್ತಮಗೊಳಿಸಲು ಬಳಸುತ್ತದೆ. ರದ್ದುಗೊಳಿಸುರದ್ದುಗೊಳಿಸು
ಧನ್ಯವಾದಗಳು. Twitter ಇದನ್ನು ನಿಮ್ಮ ಕಾಲರೇಖೆಯನ್ನು ಉತ್ತಮಗೊಳಿಸಲು ಬಳಸುತ್ತದೆ. ರದ್ದುಗೊಳಿಸುರದ್ದುಗೊಳಿಸು -
Graham Hatfull ಅವರು ಮರುಟ್ವೀಟಿಸಿದ್ದಾರೆ
Look at those plaques, a lovely webbed plate! Tomorrow’s mission: calculate a spot titer.pic.twitter.com/OBqUpEhIdO
ಧನ್ಯವಾದಗಳು. Twitter ಇದನ್ನು ನಿಮ್ಮ ಕಾಲರೇಖೆಯನ್ನು ಉತ್ತಮಗೊಳಿಸಲು ಬಳಸುತ್ತದೆ. ರದ್ದುಗೊಳಿಸುರದ್ದುಗೊಳಿಸು
ಧನ್ಯವಾದಗಳು. Twitter ಇದನ್ನು ನಿಮ್ಮ ಕಾಲರೇಖೆಯನ್ನು ಉತ್ತಮಗೊಳಿಸಲು ಬಳಸುತ್ತದೆ. ರದ್ದುಗೊಳಿಸುರದ್ದುಗೊಳಿಸು -
Graham Hatfull ಅವರು ಮರುಟ್ವೀಟಿಸಿದ್ದಾರೆ
Join the SEA-PHAGES community! Great program!https://twitter.com/HHMINEWS/status/1042444307716825091 …
 ಧನ್ಯವಾದಗಳು. Twitter ಇದನ್ನು ನಿಮ್ಮ ಕಾಲರೇಖೆಯನ್ನು ಉತ್ತಮಗೊಳಿಸಲು ಬಳಸುತ್ತದೆ. ರದ್ದುಗೊಳಿಸುರದ್ದುಗೊಳಿಸು
ಧನ್ಯವಾದಗಳು. Twitter ಇದನ್ನು ನಿಮ್ಮ ಕಾಲರೇಖೆಯನ್ನು ಉತ್ತಮಗೊಳಿಸಲು ಬಳಸುತ್ತದೆ. ರದ್ದುಗೊಳಿಸುರದ್ದುಗೊಳಿಸು -
Graham Hatfull ಅವರು ಮರುಟ್ವೀಟಿಸಿದ್ದಾರೆ
We invite applications for tenure-track faculty positions in Mathematical and Computational Life Sciences. Visit https://www.biology.pitt.edu/news-events/faculty-search-assistant-professor-0 … Please share!
ಧನ್ಯವಾದಗಳು. Twitter ಇದನ್ನು ನಿಮ್ಮ ಕಾಲರೇಖೆಯನ್ನು ಉತ್ತಮಗೊಳಿಸಲು ಬಳಸುತ್ತದೆ. ರದ್ದುಗೊಳಿಸುರದ್ದುಗೊಳಿಸು -
Graham Hatfull ಅವರು ಮರುಟ್ವೀಟಿಸಿದ್ದಾರೆ
We invite applications for 2 tenure-track faculty positions in Microbiology. Visit https://www.biology.pitt.edu/news-events/faculty-search-assistant-professor … Please share!
ಧನ್ಯವಾದಗಳು. Twitter ಇದನ್ನು ನಿಮ್ಮ ಕಾಲರೇಖೆಯನ್ನು ಉತ್ತಮಗೊಳಿಸಲು ಬಳಸುತ್ತದೆ. ರದ್ದುಗೊಳಿಸುರದ್ದುಗೊಳಿಸು -
Two Assistant Professor positions in Microbiology in the Department of Biological Sciences at the University of Pittsburgh. Apply at: https://www.biology.pitt.edu/news-events/faculty-search-assistant-professor …
ಧನ್ಯವಾದಗಳು. Twitter ಇದನ್ನು ನಿಮ್ಮ ಕಾಲರೇಖೆಯನ್ನು ಉತ್ತಮಗೊಳಿಸಲು ಬಳಸುತ್ತದೆ. ರದ್ದುಗೊಳಿಸುರದ್ದುಗೊಳಿಸು -
Roger Hendrix: Gentle Provocateurhttp://jb.asm.org/cgi/content/long/200/9/e00058-18 …
ಧನ್ಯವಾದಗಳು. Twitter ಇದನ್ನು ನಿಮ್ಮ ಕಾಲರೇಖೆಯನ್ನು ಉತ್ತಮಗೊಳಿಸಲು ಬಳಸುತ್ತದೆ. ರದ್ದುಗೊಳಿಸುರದ್ದುಗೊಳಿಸು -
Graham Hatfull ಅವರು ಮರುಟ್ವೀಟಿಸಿದ್ದಾರೆ
We invite applicants for a Senior Faculty position in Molecular Genetics and Genomics. Please share! More info: http://www.biology.pitt.edu/news-events/senior-faculty-position-molecular …
ಧನ್ಯವಾದಗಳು. Twitter ಇದನ್ನು ನಿಮ್ಮ ಕಾಲರೇಖೆಯನ್ನು ಉತ್ತಮಗೊಳಿಸಲು ಬಳಸುತ್ತದೆ. ರದ್ದುಗೊಳಿಸುರದ್ದುಗೊಳಿಸು -
Graham Hatfull ಅವರು ಮರುಟ್ವೀಟಿಸಿದ್ದಾರೆ
Does the toaster also proliferate very fast?
ಧನ್ಯವಾದಗಳು. Twitter ಇದನ್ನು ನಿಮ್ಮ ಕಾಲರೇಖೆಯನ್ನು ಉತ್ತಮಗೊಳಿಸಲು ಬಳಸುತ್ತದೆ. ರದ್ದುಗೊಳಿಸುರದ್ದುಗೊಳಿಸು -
Graham Hatfull ಅವರು ಮರುಟ್ವೀಟಿಸಿದ್ದಾರೆ
The perfect toaster for
@GHatfull @Mycobacteriumsmegmatishttps://twitter.com/herandarwin/status/952218662756323329 …
@Mycobacteriumsmegmatishttps://twitter.com/herandarwin/status/952218662756323329 … ಧನ್ಯವಾದಗಳು. Twitter ಇದನ್ನು ನಿಮ್ಮ ಕಾಲರೇಖೆಯನ್ನು ಉತ್ತಮಗೊಳಿಸಲು ಬಳಸುತ್ತದೆ. ರದ್ದುಗೊಳಿಸುರದ್ದುಗೊಳಿಸು
ಧನ್ಯವಾದಗಳು. Twitter ಇದನ್ನು ನಿಮ್ಮ ಕಾಲರೇಖೆಯನ್ನು ಉತ್ತಮಗೊಳಿಸಲು ಬಳಸುತ್ತದೆ. ರದ್ದುಗೊಳಿಸುರದ್ದುಗೊಳಿಸು -
Bill Jacobs at Albert Einstein College of Medicine has two postdoctoral positions available; Molecular Biologist, and Immunologist/Virologist. https://seaphages.org/media/forums/attachments/cd107443-66eb-4c16-86a0-802d9247b309.docx …
ಧನ್ಯವಾದಗಳು. Twitter ಇದನ್ನು ನಿಮ್ಮ ಕಾಲರೇಖೆಯನ್ನು ಉತ್ತಮಗೊಳಿಸಲು ಬಳಸುತ್ತದೆ. ರದ್ದುಗೊಳಿಸುರದ್ದುಗೊಳಿಸು -
Graham Hatfull ಅವರು ಮರುಟ್ವೀಟಿಸಿದ್ದಾರೆ
Labs in the
@PittBioSci Biology PhD program are looking for students!@RebeizLab@KevinDKohl@MTLeeLab@carlson_lab@GHatfull@ArndtLab among others Apply now http://www.biology.pitt.edu/graduate/how-apply …pic.twitter.com/ma5RZJmxse ಧನ್ಯವಾದಗಳು. Twitter ಇದನ್ನು ನಿಮ್ಮ ಕಾಲರೇಖೆಯನ್ನು ಉತ್ತಮಗೊಳಿಸಲು ಬಳಸುತ್ತದೆ. ರದ್ದುಗೊಳಿಸುರದ್ದುಗೊಳಿಸು
ಧನ್ಯವಾದಗಳು. Twitter ಇದನ್ನು ನಿಮ್ಮ ಕಾಲರೇಖೆಯನ್ನು ಉತ್ತಮಗೊಳಿಸಲು ಬಳಸುತ್ತದೆ. ರದ್ದುಗೊಳಿಸುರದ್ದುಗೊಳಿಸು -
Graham Hatfull ಅವರು ಮರುಟ್ವೀಟಿಸಿದ್ದಾರೆ
Look at what was on my office door this morning when I got in! Phage! The power of SEA-PHAGES lives on.
@phagesdb#Day1Phagepic.twitter.com/HGWPAFFhil ಧನ್ಯವಾದಗಳು. Twitter ಇದನ್ನು ನಿಮ್ಮ ಕಾಲರೇಖೆಯನ್ನು ಉತ್ತಮಗೊಳಿಸಲು ಬಳಸುತ್ತದೆ. ರದ್ದುಗೊಳಿಸುರದ್ದುಗೊಳಿಸು
ಧನ್ಯವಾದಗಳು. Twitter ಇದನ್ನು ನಿಮ್ಮ ಕಾಲರೇಖೆಯನ್ನು ಉತ್ತಮಗೊಳಿಸಲು ಬಳಸುತ್ತದೆ. ರದ್ದುಗೊಳಿಸುರದ್ದುಗೊಳಿಸು -
Graham Hatfull ಅವರು ಮರುಟ್ವೀಟಿಸಿದ್ದಾರೆ
Another great SEA-PHAGES accomplishment by
@scresawn and coauthors- http://genomea.asm.org/content/currenthttp://www.pnas.org/content/early/2017/12/05/1718188115.long …pic.twitter.com/iffD947D0m ಧನ್ಯವಾದಗಳು. Twitter ಇದನ್ನು ನಿಮ್ಮ ಕಾಲರೇಖೆಯನ್ನು ಉತ್ತಮಗೊಳಿಸಲು ಬಳಸುತ್ತದೆ. ರದ್ದುಗೊಳಿಸುರದ್ದುಗೊಳಿಸು
ಧನ್ಯವಾದಗಳು. Twitter ಇದನ್ನು ನಿಮ್ಮ ಕಾಲರೇಖೆಯನ್ನು ಉತ್ತಮಗೊಳಿಸಲು ಬಳಸುತ್ತದೆ. ರದ್ದುಗೊಳಿಸುರದ್ದುಗೊಳಿಸು -
Graham Hatfull ಅವರು ಮರುಟ್ವೀಟಿಸಿದ್ದಾರೆ
A little
@phagesdb annotation QC on a snow day in Michigan. Can’t be by the real fire, so I’ll use some screen real estate for a video of one. Nice crackling in the background!#Day1Phage@HopeCollegepic.twitter.com/XMZxArwUNc ಧನ್ಯವಾದಗಳು. Twitter ಇದನ್ನು ನಿಮ್ಮ ಕಾಲರೇಖೆಯನ್ನು ಉತ್ತಮಗೊಳಿಸಲು ಬಳಸುತ್ತದೆ. ರದ್ದುಗೊಳಿಸುರದ್ದುಗೊಳಿಸು
ಧನ್ಯವಾದಗಳು. Twitter ಇದನ್ನು ನಿಮ್ಮ ಕಾಲರೇಖೆಯನ್ನು ಉತ್ತಮಗೊಳಿಸಲು ಬಳಸುತ್ತದೆ. ರದ್ದುಗೊಳಿಸುರದ್ದುಗೊಳಿಸು -
Graham Hatfull ಅವರು ಮರುಟ್ವೀಟಿಸಿದ್ದಾರೆ
"An inclusive Research Education Community (iREC)" ... enabling real science engagement and discovery for students
@MasseyUni Read about the huge benefits for students in the new PNAS paper!#MasseyAkldScihttps://twitter.com/GHatfull/status/938112776995786752 …ಧನ್ಯವಾದಗಳು. Twitter ಇದನ್ನು ನಿಮ್ಮ ಕಾಲರೇಖೆಯನ್ನು ಉತ್ತಮಗೊಳಿಸಲು ಬಳಸುತ್ತದೆ. ರದ್ದುಗೊಳಿಸುರದ್ದುಗೊಳಿಸು
ಲೋಡಿಂಗ್ ಸಮಯ ಸ್ವಲ್ಪ ತೆಗೆದುಕೊಳ್ಳುತ್ತಿರುವಂತೆನಿಸುತ್ತದೆ.
Twitter ಸಾಮರ್ಥ್ಯ ಮೀರಿರಬಹುದು ಅಥವಾ ಕ್ಷಣಿಕವಾದ ತೊಂದರೆಯನ್ನು ಅನುಭವಿಸುತ್ತಿರಬಹುದು. ಮತ್ತೆ ಪ್ರಯತ್ನಿಸಿ ಅಥವಾ ಹೆಚ್ಚಿನ ಮಾಹಿತಿಗೆ Twitter ಸ್ಥಿತಿಗೆ ಭೇಟಿ ನೀಡಿ.













